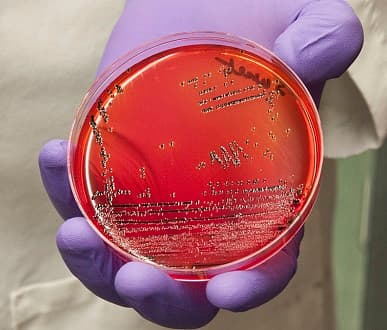

沙門氏桿菌 (Salmonella)
沙門氏桿菌廣泛存於動物界,可經由人、貓、狗、蟑螂、老鼠等途徑污染食品。所引起的食品中毒事件,在世界各地常居首位或第二位,2013 年及 2014 年在台灣排名第三,主要是因為飲食型態不同所致。
沙門氏桿菌特性
- 革蘭氏陰性 (G(-)) 桿菌。
- 具有鞭毛,善於運動。
- 好氣性或兼性厭氧菌。
- 不會形成芽胞。
- 適合生長的酸鹼值 (pH) 為 6.5~7.5 之間,在酸性環境下 (pH<4.5),生長會被抑制。
- 生存的溫度在 4~48℃ 之間,以 35~37℃ 生長最佳。
- 耐熱性低,煮沸 5 分鐘可將其殺死。
以上摘錄自:食藥署 各類食品中毒原因介紹-沙門氏桿菌
Salmonella bacteria
Photo Credit:U.S. Food and Drug Administration, photo by Michael J. Ermarth
沙門氏桿菌又稱為沙門氏菌 (Salmonella)
大多菌種為非乳糖(雙糖之一,若能被利用,則先分解為單糖)醱酵,但可發酵葡萄糖(單醣),並具有運動性及產生 H2S 的能力。沙門氏桿菌常具有 Vi(virulence,毒力)抗原,本質為多醣類的莢膜,圍繞著體抗原(O抗原),而可保護細菌體抗原免於受到抗體的攻擊,其類似克雷伯氏菌的 K 抗原(莢膜抗原)。
沙門氏桿菌不同於其他腸內菌,因為生活在動物的胃腸道以及周圍環境中,許多動物腸道中常帶有沙門氏菌,當食物或飲水被動物糞便汙染時可感染人類。在美國,甚至發生由寵物龜中得到沙門桿菌症。沙門氏桿菌感染常發生於吃了未煮熟的雞肉與雞蛋。
沙門氏菌屬是真正的致病菌
傷寒沙門桿菌 (Salmonella typhi) 並非是人畜共同感染疾病 (zoonoses) (由動物傳染給人的傳染疾病),傷寒沙門桿菌僅會經由人類患者或帶原者所傳染。沙門氏菌屬並非人類腸道中正常菌群的一部份,為真正 (frank) 致病菌,可引起下方三種疾病,有些疾病患者痊癒後,病人成為帶原者:
- 傷寒熱 (typhoid fever)
- 敗血症
- 腸炎(腹瀉)
傷寒沙門氏菌、豬霍亂沙門氏菌、腸炎沙門氏桿菌
臨床上常見的病原菌分為三種:傷寒沙門氏菌 (Salmonella typhi)、豬霍亂沙門氏菌 (Salmonella choleraesuis) 和腸炎沙門氏桿菌 (Salmonella enteritidis)。其中,腸炎沙門氏桿菌有超過 2,000 種的血清型,其命名係根據所造成的疾病。
沙門氏菌引起的感染症狀
沙門氏菌腹瀉(腸胃炎) [diarrhea, gastroenteritis] 為沙門氏菌感染最常見的症狀,會由數百種血清型中的一種非傷寒沙門氏菌所所引起,約一百萬一千萬個細菌即可引發感染。在攝食污染食物後約 18 小時(8~24 小時)發病,因此亦稱為沙門氏菌食物中毒。
症狀多為突然發作,包括下痢、發熱、腹痛、噁心、嘔吐、頭病、寒顫等,可在小腸和大腸形成發炎病灶。腹瀉通常以水瀉或較少見含有膿與少量血,約半數的病人會發燒。這種腹瀉由類似霍亂毒素的毒素所引起(水瀉),且有時亦由迴腸發炎引起黏膜腹瀉 (mucous diarrhea)。甚少出現菌血症(約 2~4%),除非在免疫缺乏病人,血液培養通常為陰性,而糞便培養常為陽性,並持續數星期。病程持續 2~3 天後可自行痊癒。最常引起此病者為腸炎沙門氏菌 (S. enteritidis serotype typhimurium) 又稱鼠傷寒桿菌 (S. typhimurium)。
沙門氏菌的感染途徑
沙門氏菌帶菌者或無明顯症狀患者的糞便常為食品的污染源,若帶菌者為食品烹調者,常持續釋出沙門氏菌,因此,營養午餐供應廠家的廚師或供饍人員,應定期檢驗其糞便是否為沙門氏菌帶菌者。許多動物如牛、鼠、雞,常有各種沙門氏菌感染,因此肉類、蛋、動物排泄物常有沙門氏菌存在。感染來源主要為受污染的食品和飲料,包括飲用水、乳製品、海鮮、蛋、肉品、家庭寵物(如貓、狗、小烏龜)等。

圖一、沙門氏菌的感染循環圖
以上摘錄自 :食品微生物檢驗技術 第 18 章 沙門氏桿菌之檢驗
食品中微生物衛生標準草案
衛福部公告「食品中微生物衛生標準」草案,其中乳及乳製品類、生鮮即食食品及生熟食混和即食食品類(如生鮮即食水產品、生鮮即食蔬果、含未全熟蛋即食產品等)、未經商業殺菌之鮮榨果蔬汁、冷凍食品及冰類、其他即食食品類(包含經復熱後即可食用之冷藏或低溫即食食品,如 18℃ 鮮食、冷藏甜點、醬料)等產品皆需檢測沙門氏菌 (Salmonella)。
延伸閱讀:食品中微生物衛生標準草案
台美檢驗 食品檢驗服務
台美檢驗 (SuperLab) 是全國唯一橫跨醫學、化學及生物相關領域的第三方公正檢驗機構,實驗室同時符合 ISO/IEC 17025、ISO/IEC 15189、ISO/IEC 17043 及 OECD GLP 等國際標準認證,其檢驗報告可與亞太實驗室認證聯盟 (APLAC MRA) 相互認可,與國際實驗室認證聯盟 (ILAC MRA) 接軌。
常見食品檢驗項目:微生物、重金屬、添加物、食品摻偽、農藥殘留、成分分析、動物用藥、營養標示等,可因應客戶需求,提供食品營養標示換算、食品標示審查、查驗登記等服務,協助您的產品符合國內外法規,歡迎來電或線上洽詢。
食品微生物常見測項
- 微生物 3 項:總生菌 + 大腸桿菌 + 大腸桿菌群
- 微生物 2 項:大腸桿菌 + 大腸桿菌群
- 微生物 2 項:黴菌酵母菌(總數計)
- 金黃色葡萄球菌(定量):致病性菌不得檢出
- 沙門氏菌(定性):致病性菌不得檢出
- 李斯特菌(定性):致病性菌不得檢出
- 肉毒桿菌:致病性菌不得檢出

你必須登入才能發表留言。